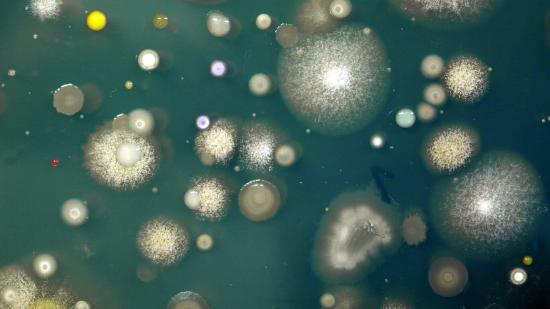
Diversidad de microorganismos presentes en una de las muestras de suelo analizadas en el proyecto MicroMundo.

¿Tensión arterial alta? El potasio puede ser más eficaz que dejar la sal, según la ciencia
Un plátano al día podría valer más que un salero menos. Un nuevo estudio demuestra que aumentar el consumo de potasio puede tener un mayor impacto en la reducción de la presión arterial que simplemente reducir la sal.